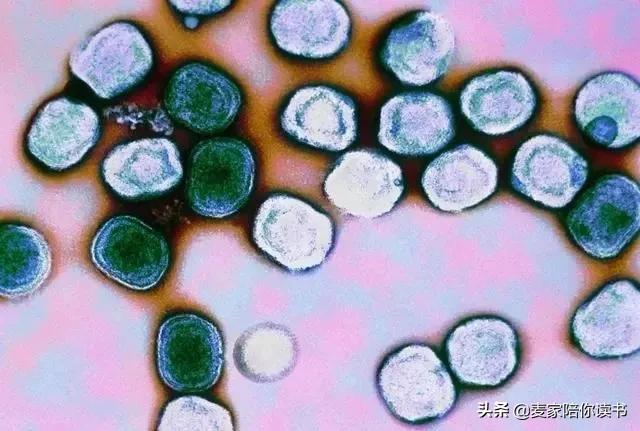
人类的记忆力是最厉害的吗,人类的记忆会随着时间变短

作者:麦家
原标题:疫情期间,回眸天花

今天,我来谈论可怕的天花恐怕是难以引起共鸣的;今天,天花对我们来说似乎更像一个可怕的传说:经常有所耳闻,但从未真正见过。
没有人会去害怕一个传说的,今天,我们只害怕新冠病毒。但我们不止有今天,我们有昨天,还有明天。
其实昨天从来没有消失,就像可怕的病毒从来没有消失一样,又如祖宗从来没有离开我们一样。那么谈谈祖宗吧,也许祖宗会告诉我们一些道德,给我们一些勇气。
确实,曾经不可一世的天花今天已经彻底远离我们了,即便有人想找到它,哪怕是它的一个病毒,也成了难以实现的奢望。
▲天花病毒
随着天花病毒绝迹的脚步声日渐远去,天花这一曾经给人类带来极大恐怖和苦难的疾病也正在慢慢被人忘却,而且有可能完全被忘却。好了伤疤忘了 痛 ,这是人类的通病。但是不管怎样,天花在人类疾病史上确实是创下“奇迹”的。
可以这么说,迄今人类遭受过的最令人恐怖的疾病除了瘟疫,就是天花了,它对我们人类的*伤杀**力跟现在人们谈起色变的新冠病毒相比,简直要强大得多,凶残得多。
导致这种病的元凶是一种痘病毒,这种毒病一旦侵入人体就会无情复制,一个病毒转眼可以在DNA周围产生上千个新病毒,其发病速度之快令人瞪目。患者所现的症状先是发热,浑身出现红色丘疹,然后变成疱疹,最后变成脓胞,出现腐烂。
这时候,病毒就会从腐烂的脓疱中蜂涌而出,感染其它细胞和周围人。所以,天花的传染性极强,只要有风就能循环传染。

▲阿兹特克人感染天花
在科学没有发现牛痘之前,一旦患上这种病只有死路一条,就连国王也不能例外。由于它防不胜防的传染性,人们最初对付它的办法是残忍地把患者丢到荒野中,甚至采用更加残忍的手段:活埋。
几个世纪前,天花让人类不得不变得残忍如兽,毫无人性可言。
即便到了上世纪初,它的死亡率依然高居20%之上,而幸存者要么破相,要么瞎眼,往往变得面目全非,很难有一个真正的幸存者。
天花不但是人类可以想象到的最恐怖的疾病,而且由于病人后期不可避免的出现全身腐烂和因此产生的恶臭常常令人恶心至极,所以它也是人类迄今见过的最恶心的疾病。
想想祖先,我们是不是得到了某些安慰?不,我们不要安慰,我们要的是疫苗,是歼灭疫情的科学*器武**。

对天花这个可怕的敌人,人类始终不停地在探寻消灭它的*器武**。
十八世纪中叶,英国的一位叫爱德华·詹拉的乡村医生,在一次实验中不经意地发现,温和的牛痘剂量可以使人产生免疫力对抗致命的天花病毒。

▲爱德华在实验牛痘法
他从牛痘中提取了世界上第一只杀死天花病毒的疫苗,事实上牛痘疫苗也是人类对付天花病毒的唯一*器武**。
但遗憾的是,爱德华·詹拉的伟大发现在当时却遭到多数人嘲笑,人们难以相信,一个无名的乡村医生会开创改变人类历史的奇迹。
坦率说,这种愚蠢人类已经不是第一次犯,也不是最后一次。和被当众烧死的布鲁诺比,仅仅被人嘲笑的詹拉确实要幸运得多了,但对全人类来说,这却是一个巨大的不幸。
对詹拉的嘲笑没有在短时间内得到制止,而是直到200年后的1966年5月,世界卫生组织终于通过了一项里程碑式的决议:要依靠“牛痘疫苗”和不多的“200万美元”,在世界范围内彻底消灭天花。

▲给孩童接种疫苗抵抗天花
当时全球每年患天花的病人有一千多万,如果要彻底消灭天花,就意味着要给所有天花患者,包括他们周围的所有人都注射牛痘疫苗,这个人数达十亿之多。
这些人分布在世界各大洲,主要集中在一些充满饥荒和战争的国家或地区,而且因为羞于见人,那些天花患者常常把自己藏匿起来。
所以,要完成消灭天花的任务,可想有多么困难。当时许多科学家都认为这是不可能的,甚至连世界卫生组织的总干事也深表怀疑。但谁也想不到,在具体实施过程中,这项工作并没有想象的那么艰难。
虽然遇到各种各样的困难,但总的来说显得异乎寻常的顺利,不论是发达还是落后国家,不论是政府官员还是黎民百姓,人们对围剿天花的“战役”表现出了一种简直难以想象的大同和博爱精神。这从另外一方面也说明了天花给人类投下的阴影有多大、多深。
任何战役都会诞生一些英雄。在这场特殊“战役”中诞生的英雄是无数的,世界上著名的有马亨·德拉辛,西罗·夸德卢思,比尔福奇,尼可尔·格拉塞特等。
其中唐拉德·亨德森完全称得上是英雄中的英雄,他不但是消灭天花计划的倡导者,也是具体实施围剿战役的组织者。

▲唐拉德·亨德森
“战役”持续的时间是漫长的,但“枪声”一年比一年稀落下来,到了七十年代中期,枪声已变得零星。为了找到所有天花患者,世界卫生组织最后采用了重金悬赏的办法。应该说,这一办法获得了绝妙的效果,它使那些深藏不露的天花患者都成了“翁中之鳖”。
1977年,人们在索马里找到了最后一例天花患者。1980年,世界卫生组织宣告:天花已经绝迹!

▲世卫组织WHO郑重宣布了一个消息——人类已经彻底消灭了天花
今天,我们每一个人手臂上无一例外都有一块指甲一般大小的痘疤,这是人类为消灭天花而共同刻下的记号。
消灭天花,是世界医疗史上的一大奇迹,所有参与这项工作的专家和医疗工作者都认为这是他们一生中干的最伟大的一件事。

至上世纪七十年代末,天花这一猖獗几个世纪的病魔终于失尽往日的威风,它的每一个病毒都被人类束手就擒,装入瓶子,有的成了博物馆的展品,更多的被关在世界各地的实验室里,成了科学家进行探索、研究的玩物。

如果那时大家意见一致,彻底销毁天花病毒只是举手之劳。
在每年两度的日内瓦“世卫会”上,不乏有人指出:保留天花病毒,哪怕是在封闭的实验室里,都是危险的。
所以要求把留存在世上的天花病毒统统销毁掉。但也有人希望保留它,让科学家和时间共同来解开它罕见的“恐怖之谜”。争论的结果是没有行动,还在继续争论。与此同时,灾难却降临了。
事情发生在伯明翰的一家研究天花和其他痘病毒的实验所里,具体说是保存天花病毒的实验室的楼上房间里,这里是医务摄影师詹内特·巴克的办公室。
谁也不知道楼下的天花病毒是怎么从瓶子里窜到巴克那里去的,也许是病毒泄出瓶子后,沿气道或什么管子向上运动,钻进了巴克的办公室,使她不幸成了世界上为天花夺走性命的最后一位天花病人。

▲最后一位天花病人:詹内特·巴克
这一事件的发生,促使世界卫生组织把争论双方的意见折中作出了一个决定:世界各地实验室不再保存和研究天花病毒,所有天花病毒都必须集中保存到美国亚特兰大疾病控制中心和前苏联莫斯科病毒预防研究所。
这两家全世界最安全的研究机构,都置身在人群以外数百公里的荒凉中,与世隔绝,鲜为人知。
在那里,科学家们每天穿着加压的宇航服,戴着面罩,背着氧气筒,像在遥远的月球上一样,谨慎地和可怕的天花病毒打着交道。

即便这样,人们还是提心吊胆,因为它毕竟不在月球上,只是在离人群稍远的某个角落里。
这个角落对那些无所不为的恐怖分子来说不是无法抵达的。无论从哪方面说,天花病毒向来就是制造世界恐怖的头号*器武**,人们没有理由不担心恐怖组织丧尽天良地拿它来威胁人类,制造极端恐怖。
当天花病毒和恐怖分子的话题越绞越紧时,西方一些政治家要求销毁天花病毒的态度变得越发强硬。
1984年初,世界卫生组织在美国和前苏联有关官员的建议要求下,第一次作出了销毁天花病毒的决定,销毁时间明确为:1993年底。
之所以留有将近十年时间,是迫于某些科学家的强烈呼吁,因为人类依然生活在其他疾病的恐怖中。
一些科学家坚信,只要敲开天花病毒的“恐怖之谜”,就能帮助人类摆脱眼前某些不治顽症。但属于他们的时间并不多。

光阴荏苒,转眼到了1993年底,有关天花病毒的研究工作并没有取得实质性进展,但销毁天花病毒的最后期限已不容置疑地临近。
国际专家委员会为此制定了销毁它的详细时间、地点,包括手段——采用全密封高压消毒锅,加温至120度,煮烧45分钟。
眼看着天花病毒即将诀别人类,但就在这节骨眼上,科学家们对它的研究获得了破天荒的进展,他们惊讶地发现:天花病毒有和人类相对应的基因序列。

▲显微镜下的天花病毒
进一步探寻,科学家又发现,天花病毒具有偷取人体免疫和炎症反应指令和模拟人类基因的特异功能。
这简直令人目瞪口呆!我们知道,人体免疫过程是依靠一个精微的信息系统完成的,当细胞受病毒感染后,它们会发出呼救信号,大量蛋白分子从感染细胞中疯涌而出,将周围健康细胞表面整齐排列的感受器纷纷锁住,并把报警信号传给健康细胞,让它们产生发烧、炎症,甚至自毁,致使病毒不能传播。
但天花病毒却具有制造人体细胞感受器的神奇功能,这样当呼救信号传及健康细胞时,天花病毒制造的伪感受器就可能将它截获,致使呼救信号完全中断,健康细胞因此难以作出的发烧和炎症反应,从而使天花病毒得以生存下来。
而从非典发迹的新冠病毒,其实玩的是同一伎俩:一顶冠状帽子伪装了病毒真身,让“警察”熟视无睹,从而“星星之火,可以燎原”。
免疫系统是人体抗击和围歼任何入侵细菌和病毒的防卫机制,它所具备的奥秘和复杂性,虽然科学家们经过了上百年研究,却依然一无所知。
而天花病毒通过在人类身上几千年的盘踞和肆虐,已经悄然揭开了人体免疫系统的秘密:这在其它任何病毒中都是可望不可及的。
至此,科学家们更加坚信,天花病毒对人类是无价之宝,不应该把它销毁。

▲被封存的天花病毒
毫无疑问,通过研究天花病毒在人体免疫系统中的动作“原理”,人类就有可能探寻到人体免疫系统的工作原理,从而有助于我们研制出对抗其他感染的新药。
由此可见,对天花病毒特异功能的发现,其意义太重大了。于是原本的“诀别行动”随之搁浅下来。
科学家们靠自己辛勤耕耘出来的丰硕成果赢得了进一步利用天花病毒的宝贵时间。但对要求销毁天花病毒的人来说,等于是延长了他们的恐怖时间。
探寻天花病毒奥秘的工作一刻也没有停止,同时要求销毁天花病毒的呼声也一刻都没有中止。
人类在对天花病毒销毁与否的态度上始终存在着矛盾,但不管怎样,矛盾的双方都希望在规定销毁的最后期限内,能将天花病毒的特异功能占为人类己有。然而,这又谈何容易。
正当科学家们开始日渐了解天花病毒复杂的结构,思索从中我们可以学到什么东西的时候,有关销毁天花病毒的讨论也日渐趋于一致。
1996年5月24日,世界卫生组织再次明确了销毁全部天花病毒的最后期限日:1999年6月30日。

要想打开一个未知世界,三年时间当然谈不上宽裕。在紧迫的时间面前,无论是美国、俄罗斯还是中国的科学家们,都一刻不停地进行着非常紧张又细致的探寻工作。

在美国,一家生物技术公司投资了上亿美元用来研究天花病毒的特异功能,希望从中引出一种全新的制药和治疗方法。
他们的努力没有白费,经过反复探索,一种模拟天花病毒偷取人体免疫指令而研制的新药终于诞生了。这种药对类风湿性关节炎和心脏病具有全新的疗效。
如果说科学家是催生这种新药问世的父亲,那么天花病毒就称得上是孕育这一新药的母亲。新药成功问世这一消息传到地球的另一边,让俄罗斯的科学家们也激动不已。
确实,在这个世上,对天花病毒抱有热情的人似乎正在变得越来越少,而且规定的最后期限也正在日夜逼近。
新药诞生在这个时候,无疑是对那些准备死守销毁期限不放的人,尤其是一些蒙受恐怖组织巨大压力的政治家敲响了“放宽期限”的警钟。事实上,人类对天花病毒宝贵价值的发掘工作,至此仅仅是才刚开始。
科学家们发现,天花病毒大约有50-100种基因与人体防御系统相互作用,而用来开发治疗类风湿关节炎和心脏病新药的基因只是其中的两种而已,剩下的基因已有某种迹象表明,将为我们攻克白血病、急性艾滋病及大脑疾病提供非它莫属的帮助。
至于还有的很多种基因,目前谁也不知道里面包藏着什么宝贝。一些科学家因此就严正指出:如果就这样销毁它就等于焚书;这本书人类还远远没有读完呢;这本书里说不定珍藏人类战胜疾病的无限希望。

但要求销毁天花病毒的声音也不是无力的,他们认为:烧掉“这本书”等于烧掉人类对恐怖组织的一大恐惧,而留下它等于留下了心腹之患。一旦天花病毒落入恐怖分子手中,就可能给人类带来灾难。
在美国,30岁以下的人几乎都未接种牛痘,这些人对天花病毒没有任何免疫能力。天花病毒一旦投放在这些人中间,就完全可能造成一起世界范围的天花灾难。
这种灾难的降临,其危害将是无法估量的,即便以“这本书”全部的无价之宝来抵偿也难以偿清。
如果说这声音更多的是西方某些政治家发出的,那么在科学家中间也不乏要求销毁天花病毒的呼吁声,他们的理由是:
现在整个天花病毒全都被克隆成质体和基因序列,所以有关贮存在天花病毒中的信息完全可以通过研究它的克隆基因来获得。这也就是说,保留天花病毒已纯属多余。
应该说这个呼吁销毁的“声音”是有相当威力的,在它的作用下,销毁天花病毒似乎是指日可待的事了。

但要求保留天花病毒的人同样找到了反驳的有力*器武**,他们指出:即便销毁了保存的天花病毒,也不是绝对的销毁了。
因为一些埋葬在冰雪中的天花患者的死尸随时都会暴露出来,在这些尸体上极可能藏有活性的天花病毒。
此外,从世界各地的实验室来说,也不能彻底排除有秘密保存天花病毒的,一位叛逃到美国的俄罗斯间谍说:据他了解,俄罗斯至少还有两个实验室偷偷地保存着天花病毒。
还有,最近有科学家发现,猴子身上的一种痘病毒在血缘上与天花非常相似,虽然它现在还没有直接危害人类,而且其传染性很差,但谁又能保证它不会变化,不会给人类再次带来天花。
更主要的是,现在DNA的合成专家可以在一夜之间制造出1000个DNA的核苷酸。在不久的将来,以这些核甘酸合成天花病毒不是不可能的。
这就是说,天花病毒事实上已经到无法销毁的地步了,你今天销毁它,明天就可能有人将它重新制造出来的,而且新合成的天花病毒必将更加危险可怕,因为它是一种新的病毒。
以上种种理由表明,销毁美国和俄罗斯两大研究所里的天花病毒是不可取的,因为这并不能达到彻底销毁天花病毒的目的。

换言之,既然这样做不能达到彻底销毁天花病毒的目的,这样做又有何必要呢?
不论是呼吁销毁也好,还是要求保留也罢,双方的理由都是充分的。在双方没有绝对说服、压倒对方的情况下,出现一些对抗行为是难免的。录用以下这组资料是最能说明对抗的激烈的——
1999年4月,美国首先向世界卫生组织发难,宣布:他们将更改销毁天花病毒的最后期限,继续保留一段时间。
1999年5月,世界卫生组织申明:销毁计划不可更改,美俄双方必须在原定期限内,即在本年度6月30日前全部销毁天花病毒。
1999年6月,世界卫生组织又重申这一要求。几天后,俄罗斯也向世界卫生发难,表示他们也不愿意这样做。
美俄双方的坚决态度,促使世界卫生不得不再次更改销毁时间,将最后期限改为:2002年12月31日。
2014年7月,美国食品药品监督管理局的一位科学家在马里兰州国立卫生研究院的冷藏室中发现了6瓶被遗忘的天花病毒。

▲马里兰州国立卫生研究院
科学家们相信,类似的“漏网之鱼”一定还在更多角落存在。这是好是坏,没有人能知道,也许只有上帝知道。
天花,这个曾经给人类带来巨大灾难和恐怖的恶魔,今天,它虽然已被人类完全制服,却依然让人类感到无所适从的头痛,和隐隐的不安。
但愿,人类为它的巨大付出能给我们带来福音。但愿,科学家们能从它的黑底找到破译新冠病毒的密钥。
但愿,武汉能早日剿灭疫情。但愿,我们不要忘记今天。
此刻我神奇地听到种在左手臂上的痘疤对我说:你们人类所以能消灭天花病毒,是因为你们把我刻在了手臂上,你们不敢忘掉它,但你们人类的记性并不好,经常忘记昨天。